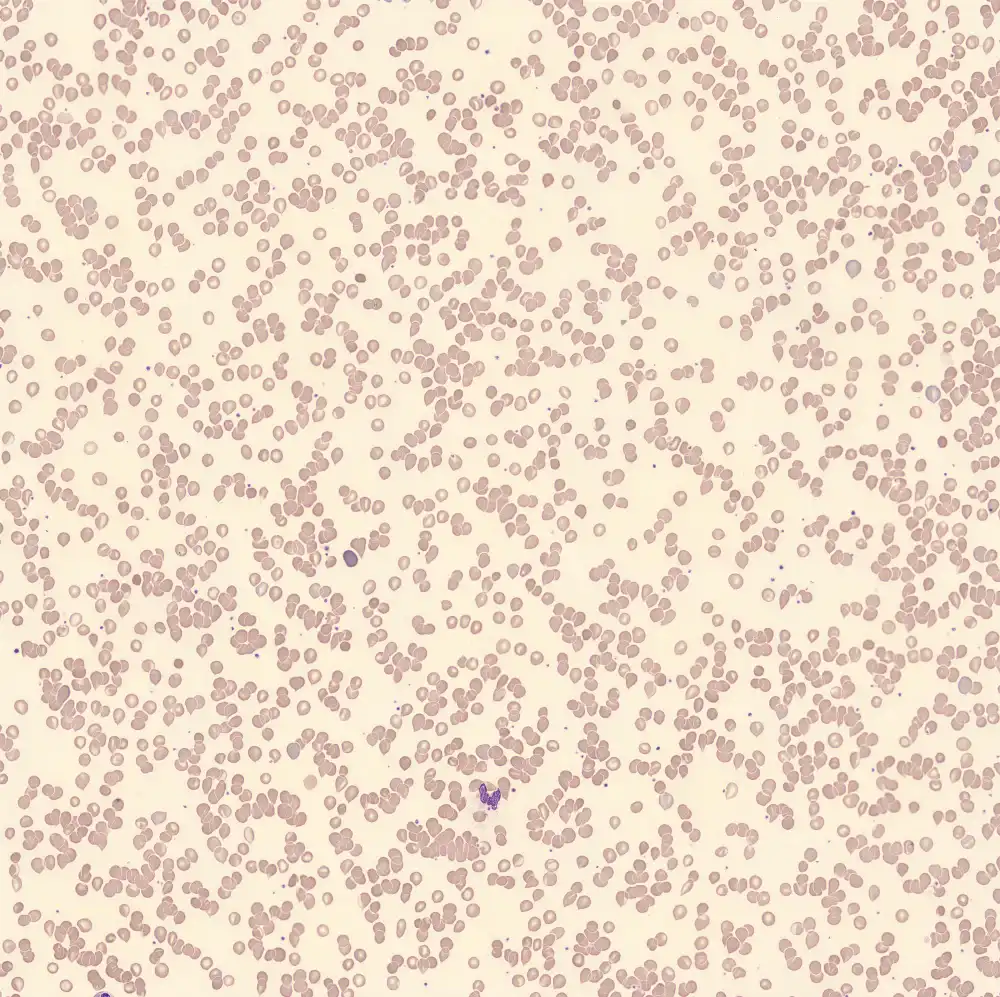

Teardrop cells
Synonyms: Dacrocytes
Droplet or pear-shaped erythrocytes (dakryozytes) arise from locally reduced deformability, for example, due to inclusions, or from irreversible deformation during prolonged passage through the spleen. When a smear artifact can be excluded, detection of tear drop cells in peripheral blood is strongly associated with severe underlying bone marrow pathology, particularly primary or secondary myelofibrosis, bone marrow infiltration (as in carcinomatosis, leukemia or myelodysplastic syndromes) and extramedullary hematopoiesis.






Dacrocytosis
If the tear drop cells have a pathophysiological basis, the cells lie in different directions.
Dacrocytosis

Pseudo-Dacrocytosis
In the case of a smear artifact, the cells lie in the smear direction. As shown below, the smearing direction was from top to bottom.